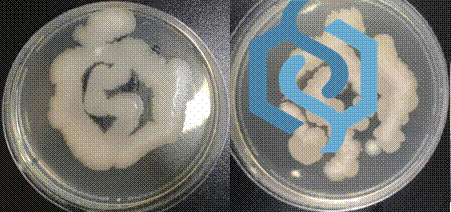
6EA2

12月12日晚上七点,由ebook漫画
学生创新创业中心主办和ebook漫画
承办的第三届ebook漫画
大学生生物学实验技能大赛颁奖典礼在ebook漫画
108报告厅圆满举行。ebook漫画
院长谭拥军、学院党委副书记陈树芸、评委孟祥贤、葛行义、廖红东、高强、及潘昳锦出席本次颁奖典礼。典礼由郭新红主任主持。

师生合影留念

谭拥军院长讲话
本次大赛得到全校学生的积极响应,由来自ebook漫画
、化学化工学院、材料科学与工程学院等十四个学院、六十余名同学报名参加。本次比赛内容为:微生物平板划线操作技术及平板划线绘制生物院院徽图案。参赛者在规定时间内完成实验操作和结果汇报,选手成绩由实验结果的质量及选手的实际操作能力评定,最终根据成绩确定获奖等级。参赛者认真仔细地完成了实验操作各个环节,详细准确的记录了实验结果。组委会的精心组织,评委老师专业严谨的评审,工作人员与学生志愿者的周到服务确保了大赛的顺利进行和圆满完成。最终赛出一等奖5名,二等奖7名,三等奖8名。

颁奖现场

一等奖获奖者合影留念

二等奖获奖者合影留念

三等奖获奖者合影留念
本次大赛圆满完成,学院将以此为契机继续强化学生的创新实践能力,促进理论和实践的结合,不断培养实践能力强、综合素质高、创新意识强的精英人才。

开幕式合影


比赛现场
结果展示
文 白克勤
图 吴楠